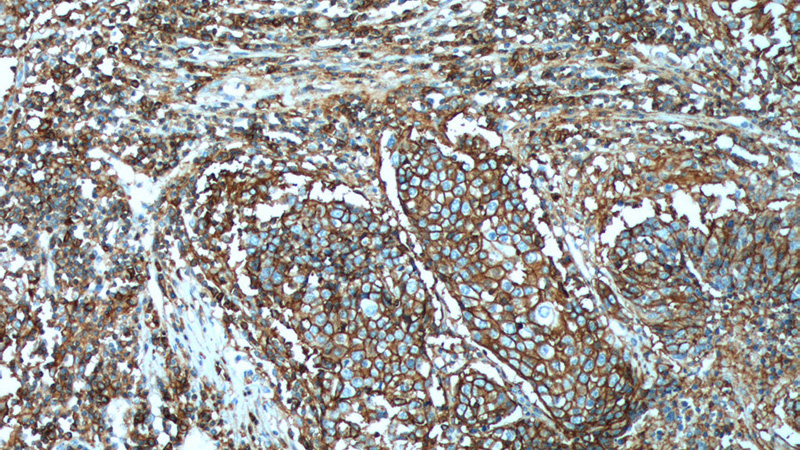
Immunohistochemistry of paraffin-embedded human lung cancer tissue slide using Catalog No:109124(CD44 Antibody) at dilution of 1:200 (under 10x lens). heat mediated antigen retrieved with Tris-EDTA buffer(pH9).

-
Product Name
CD44 antibody
- Documents
-
Description
CD44 Rabbit Polyclonal antibody. Positive IP detected in HeLa cells. Positive WB detected in HeLa cells, MCF7 cells, mouse thymus tissue, Raji cells. Positive FC detected in HeLa cells. Positive IHC detected in human lung cancer tissue, human colon cancer tissue, human skin tissue. Positive IF detected in HepG2 cells, MCF-7 cells. Observed molecular weight by Western-blot: 80-95 kDa
-
Tested applications
ELISA, IP, FC, IHC, WB, IF
-
Species reactivity
Human, Mouse; other species not tested.
-
Alternative names
CD44 antibody; CD44 antigen antibody; CDW44 antibody; CSPG8 antibody; ECMR III antibody; Epican antibody; HCELL antibody; Heparan sulfate proteoglycan antibody; Hermes antigen antibody; HUTCH I antibody; Hyaluronate receptor antibody; LHR antibody; MC56 antibody; MDU2 antibody; MDU3 antibody; MIC4 antibody; MUTCH I antibody; PGP 1 antibody; PGP I antibody; Pgp1 antibody; PhagOCytic glycoprotein 1 antibody; PhagOCytic glycoprotein I antibody
-
Isotype
Rabbit IgG
-
Preparation
This antibody was obtained by immunization of CD44 recombinant protein (Accession Number: NM_001001389). Purification method: Antigen affinity purified.
-
Clonality
Polyclonal
-
Formulation
PBS with 0.02% sodium azide and 50% glycerol pH 7.3.
-
Storage instructions
Store at -20℃. DO NOT ALIQUOT
-
Applications
Recommended Dilution:
WB: 1:500-1:5000
IP: 1:200-1:2000
IHC: 1:50-1:500
IF: 1:50-1:500
-
Validations

HeLa cells were subjected to SDS PAGE followed by western blot with Catalog No:109124(CD44 antibody) at dilution of 1:1000

1X10^6 HeLa cells were stained with 0.2ug CD44 antibody (Catalog No:109124, red) and control antibody (blue). Fixed with 4% PFA blocked with 3% BSA (30 min). Alexa Fluor 488 -Goat anti-Rabbit IgG with dilution 1:100.

Immunofluorescent analysis of (-20°C Ethanol) fixed HepG2 cells using Catalog No:109124(CD44 Antibody) at dilution of 1:50 and Alexa Fluor 488-congugated AffiniPure Goat Anti-Rabbit IgG(H+L)
Immunohistochemistry of paraffin-embedded human lung cancer tissue slide using Catalog No:109124(CD44 Antibody) at dilution of 1:200 (under 10x lens). heat mediated antigen retrieved with Tris-EDTA buffer(pH9).

Immunohistochemistry of paraffin-embedded human lung cancer tissue slide using Catalog No:109124(CD44 Antibody) at dilution of 1:200 (under 40x lens). heat mediated antigen retrieved with Tris-EDTA buffer(pH9).

IP Result of anti-CD44 (IP:Catalog No:109124, 5ug; Detection:Catalog No:109124 1:800) with HeLa cells lysate 2500ug.
-
Background
CD44 is a type I transmembrane glycoprotein that mediates cell-cell and cell-matrix interactions through its affinity for hyaluronic acid (HA) and possibly also through its affinity for other ligands. Adhesion with HA plays an important role in cell migration, tumor growth and progression. CD44 is also involved in lymphocyte activation, recirculation and homing, and in hematopoiesis. This protein exists in multiple isoforms generated by alternative RNA splicing and undergoes extensive post-translational modifications.
-
References
- Yang CF, Yang GD, Huang TJ. EB-virus latent membrane protein 1 potentiates the stemness of nasopharyngeal carcinoma via preferential activation of PI3K/AKT pathway by a positive feedback loop. Oncogene. 2015.
- Han S, Guo J, Liu Y. Knock out CD44 in reprogrammed liver cancer cell C3A increases CSCs stemness and promotes differentiation. Oncotarget. 6(42):44452-44465. 2015.
- Kingham E, White K, Gadegaard N, Dalby MJ, Oreffo RO. Nanotopographical cues augment mesenchymal differentiation of human embryonic stem cells. Small (Weinheim an der Bergstrasse, Germany). 9(12):2140-51. 2013.
- Zhang Z, Miao L, Sun W. Wentilactone B from Aspergillus wentii induces apoptosis and inhibits proliferation and migration of human hepatoma SMMC-7721 cells. Biological & pharmaceutical bulletin. 35(11):1964-71. 2012.
- Yang CF, Peng LX, Huang TJ. Cancer stem-like cell characteristics induced by EB virus-encoded LMP1 contribute to radioresistance in nasopharyngeal carcinoma by suppressing the p53-mediated apoptosis pathway. Cancer letters. 344(2):260-71. 2014.
- Huang CF, Xu XR, Wu TF, Sun ZJ, Zhang WF. Correlation of ALDH1, CD44, OCT4 and SOX2 in tongue squamous cell carcinoma and their association with disease progression and prognosis. Journal of oral pathology & medicine : official publication of the International Association of Oral Pathologists and the American Academy of Oral Pathology. 43(7):492-8. 2014.
- Liu D, Sun J, Zhu J, Zhou H, Zhang X, Zhang Y. Expression and clinical significance of colorectal cancer stem cell marker EpCAM(high)/CD44(+) in colorectal cancer. Oncology letters. 7(5):1544-1548. 2014.
- He KF, Zhang L, Huang CF. CD163+ tumor-associated macrophages correlated with poor prognosis and cancer stem cells in oral squamous cell carcinoma. BioMed research international. 2014:838632. 2014.
Related Products / Services
Please note: All products are "FOR RESEARCH USE ONLY AND ARE NOT INTENDED FOR DIAGNOSTIC OR THERAPEUTIC USE"
